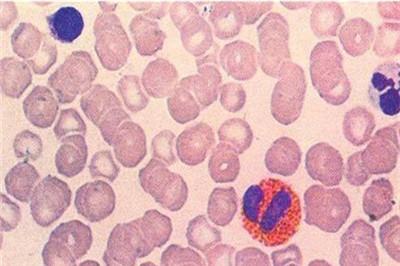
白血球高是怎么回事 小心是这几种病找上你！

孕妇白细胞偏高是什么原因
2021年01月21日 15:00阅读次数:0
孕妇白细胞偏高是什么原因?一般来说体内白细胞升高可能是身体出现炎症等问题,现在孕妇白细胞偏高是什么原因?也是身体出问题了吗?
1
孕妇白细胞偏高是什么原因
1、生理性升高,正常情况。孕妇白细胞升高可能是属于生理性的,由于妊娠期间,孕妇的血液系统会发生变化,从而会出现轻度增加的现象,不用过于担心。
2、病理性升高,可能有感染。如果你近期有尿频、尿急的症状,可能是存在尿路感染的原因。如果你近期有咳嗽的症状,可能是呼吸道有炎症,因此需要结合你的临床症状做出综合判断。

2
孕妇白细胞高对胎儿有影响吗
因为在怀孕期间,妈妈的血液系统会发生一些改变,其白细胞和没有怀孕的女性相比会处于相对较高的水平,通常会超过10000个/mm^3,甚至最高的时候到15000个/mm^3,偶尔也有到20000个/mm^3的时候。但是白细胞过高,应警惕有没有一些其它的病变。如果只是单纯的升高,并没有合并血液系统的疾病,可认为没有多大的影响。但如果合并有白血病或者其它血液系统疾病时,疾病本身就会对孩子造成影响。如果白血病中白细胞超过30000个/mm^3,甚至50000个/mm^3,对妈妈而言可发生白细胞堵塞,堵塞甚至会发生在胎盘,随时有胎死宫内的风险。
但通常如果白细胞没有超过20000个/mm^3,一般对孩子并没有大的影响。而在白细胞高的时候,要去寻找白细胞高的原因,尤其是要注意排除一些致死性的原因,比如急性白血病等。另外,最常见的也有可能是在怀孕期间生理性升高,以前在10000个/mm^3以下,或者在(10000-15000)个/mm^3之间波动,也一般认为是正常的。

3
- 白细胞
- 怀孕注意事项

19:24
19:24
 17:49
17:49
 10:02
10:02
 12:57
12:57
 17:36
17:36
 10:15
10:15











还没有人评论哦,赶紧抢一个沙发吧!